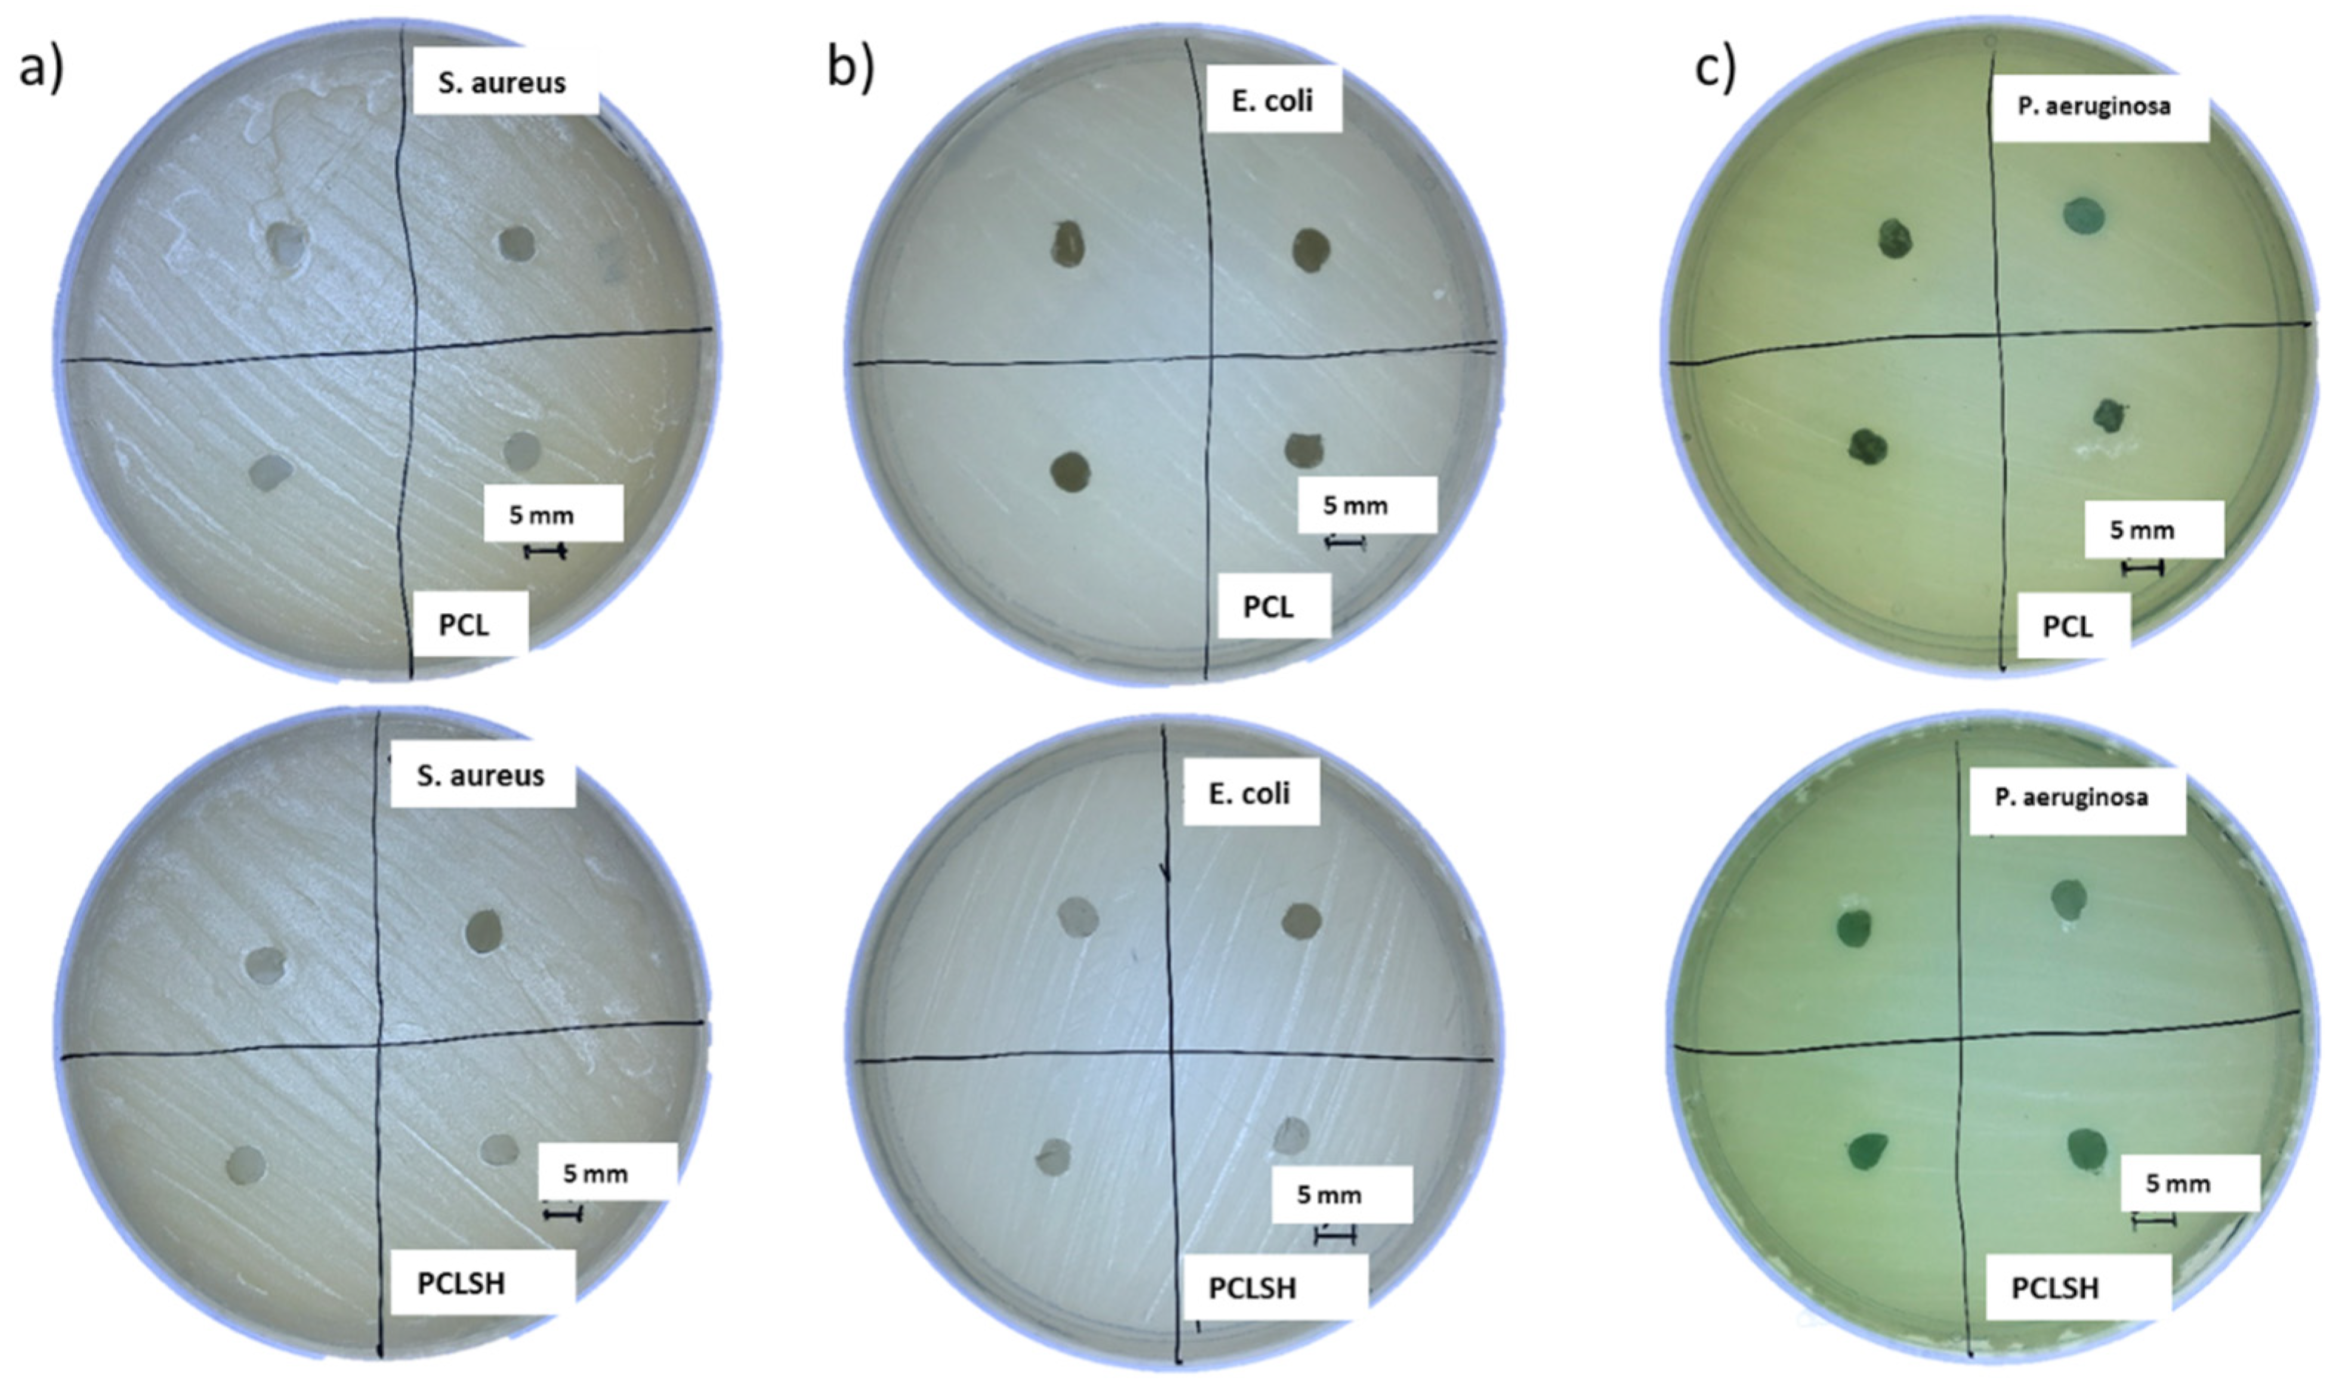
Materials 15 00089 g009

Preliminary Characterization of a Polycaprolactone-SurgihoneyRO Electrospun Mesh for Skin Tissue Engineering
Abstract
:1. Introduction
2. Materials and Methods
2.1. Material Preparation
2.2. Electrospun Mesh Fabrication
2.3. Morphological and Topographical Analysis
2.4. X-ray Diffraction
2.5. Fourier Transform Infrared and X-ray Photoelectron Spectroscopy
2.6. Wettability
2.7. Tensile Mechanical Characterisation
2.8. Degradation and Swelling
2.9. Cell Metabolic Activity and Viability
2.10. Glucose and Hydrogen Peroxide Concentration
2.11. Antibacterial Analysis
2.12. Statistical Analysis
3. Results and Discussion
3.1. Morphology and Topography
3.2. Mesh Crystallinity
3.3. Chemical Analysis
3.4. Mesh Wettability
3.5. Mechanical Analysis
3.6. Swelling and Degradation
3.7. Cell Metabolic Activity and Viability
3.8. Antibacterial Performance of Electrospun Meshes
4. Conclusions
Supplementary Materials
Author Contributions
Funding
Institutional Review Board Statement
Informed Consent Statement
Data Availability Statement
Acknowledgments
Conflicts of Interest
References
- Timmons, J. Skin function and wound healing physiology. Wound Essent. 2006, 1, 8–17. [Google Scholar]
- Dias, J.R.; Granja, P.L.; Bártolo, P.J. Advances in electrospun skin substitutes. Prog. Mater. Sci. 2016, 84, 314–334. [Google Scholar] [CrossRef]
- Pereira, R.F.; Bártolo, P.J. Traditional Therapies for Skin Wound Healing. Adv. Wound Care 2016, 5, 208–229. [Google Scholar] [CrossRef] [PubMed] [Green Version]
- Velnar, T.; Bailey, T.; Smrkolj, V. The Wound Healing Process: An Overview of the Cellular and Molecular Mechanisms; SAGE: Los Angeles, CA, USA, 2009; pp. 1528–1542. [Google Scholar]
- Olczyk, P.; Mencner, Ł.; Komosinska-Vassev, K. The Role of the Extracellular Matrix Components in Cutaneous Wound Healing. BioMed Res. Int. 2014, 2014, 747584. [Google Scholar] [CrossRef] [Green Version]
- Bae, W.-G.; Kim, J.; Choung, Y.-H.; Chung, Y.; Suh, K.Y.; Pang, C.; Chung, J.H.; Jeong, H.E. Bio-inspired configurable multiscale extracellular matrix-like structures for functional alignment and guided orientation of cells. Biomaterials 2015, 69, 158–164. [Google Scholar] [CrossRef]
- Bar-On, B.; Wagner, H.D. Structural motifs and elastic properties of hierarchical biological tissues—A review. J. Struct. Biol. 2013, 183, 149–164. [Google Scholar] [CrossRef]
- Theocharis, A.D.; Skandalis, S.S.; Gialeli, C.; Karamanos, N.K. Extracellular matrix structure. Adv. Drug Deliv. Rev. 2016, 97, 4–27. [Google Scholar] [CrossRef]
- Wildt, d.B.W.M.; Ansari, S.; Sommerdijk, N.A.J.M.; Ito, K.; Akiva, A.; Hofmann, S. From bone regeneration to three-dimensional in vitro models: Tissue engineering of organized bone extracellular matrix. Curr. Opin. Biomed. Eng. 2019, 10, 107–115. [Google Scholar] [CrossRef]
- Urbanczyk, M.; Layland, S.L.; Schenke-Layland, K. The role of extracellular matrix in biomechanics and its impact on bioengineering of cells and 3D tissues. Matrix Biol. 2020, 85–86, 1–14. [Google Scholar] [CrossRef]
- Frykberg, R.G.; Banks, J. Challenges in the Treatment of Chronic Wounds. Adv. Wound Care 2015, 4, 560–582. [Google Scholar] [CrossRef] [Green Version]
- Han, G.; Ceilley, R. Chronic Wound Healing: A Review of Current Management and Treatments. Adv. Ther. 2017, 34, 599–610. [Google Scholar] [CrossRef] [Green Version]
- Guest, J.F.; Fuller, G.W.; Vowden, P. Cohort study evaluating the burden of wounds to the UK’s National Health Service in 2017/2018: Update from 2012/2013. BMJ Open 2020, 10, e045253. [Google Scholar] [CrossRef]
- Guest, J.F.; Fuller, G.W.; Edwards, J. Cohort study evaluating management of burns in the community in clinical practice in the UK: Costs and outcomes. BMJ Open 2020, 10, e035345. [Google Scholar] [CrossRef] [Green Version]
- Roope, L.S.J.; Smith, R.D.; Pouwels, K.B.; Buchanan, J.; Abel, L.; Eibich, P.; Butler, C.C.; Tan, P.S.; Walker, A.S.; Robotham, J.V.; et al. The challenge of antimicrobial resistance: What economics can contribute. Science 2019, 364, eaau4679. [Google Scholar] [CrossRef]
- Nathan, C.; Cars, O. Antibiotic Resistance—Problems, Progress, and Prospects. N. Engl. J. Med. 2014, 371, 1761–1763. [Google Scholar] [CrossRef]
- Nathan, C. Resisting antimicrobial resistance. Nat. Rev. Microbiol. 2020, 18, 259–260. [Google Scholar] [CrossRef]
- O’Neill, J. Tackling Drug-Resistant Infections Globally: Final Report and Recommendations; The Review on Antimicrobial Resistance; Government of the United Kingdom: London, UK, 2016. [Google Scholar]
- Percival, S.L. Restoring balance: Biofilms and wound dressings. J. Wound Care 2018, 27, 102–113. [Google Scholar] [CrossRef]
- Reddy, J.V.; Radhakrishnan, S.; Ravichandran, R.; Mukherjee, S.; Balamurugan, R.; Sundarrajan, S.; Ramakrishna, S. Nanofibrous structured biomimetic strategies for skin tissue regeneration. Wound Repair Regen. 2013, 21, 1–16. [Google Scholar] [CrossRef]
- Groeber, F.; Holeiter, M.; Hampel, M.; Hinderer, S.; Schenke-Layland, K. Skin tissue engineering—In vivo and in vitro applications. Adv. Drug Deliv. Rev. 2011, 63, 352–366. [Google Scholar] [CrossRef]
- Vig, K.; Chaudhari, A.; Tripathi, S.; Dixit, S.; Sahu, R.; Pillai, S.; Dennis, V.A.; Singh, S.R. Advances in skin regeneration using tissue engineering. Int. J. Mol. Sci. 2017, 18, 789. [Google Scholar] [CrossRef] [PubMed]
- Augustine, R. Skin bioprinting: A novel approach for creating artificial skin from synthetic and natural building blocks. Prog. Biomater. 2018, 7, 77–92. [Google Scholar] [CrossRef] [PubMed] [Green Version]
- Pereira, R.F.; Sousa, A.; Barrias, C.C.; Bayat, A.; Granja, P.L.; Bártolo, P.J. Advances in bioprinted cell-laden hydrogels for skin tissue engineering. Biomanuf. Rev. 2017, 2, 1. [Google Scholar] [CrossRef] [Green Version]
- Zahedi, P.; Rezaeian, I.; Ranaei-Siadat, S.O.; Jafari, S.H.; Supaphol, P. A review on wound dressings with an emphasis on electrospun nanofibrous polymeric bandages. Polym. Adv. Technol. 2010, 21, 77–95. [Google Scholar] [CrossRef]
- Keirouz, A.; Chung, M.; Kwon, J.; Fortunato, G.; Radacsi, N. 2D and 3D electrospinning technologies for the fabrication of nanofibrous scaffolds for skin tissue engineering: A review. WIREs Nanomed. Nanobiotechnol. 2020, 12, e1626. [Google Scholar] [CrossRef] [Green Version]
- Vyas, C.; Pereira, R.; Huang, B.; Liu, F.; Wang, W.; Bartolo, P. Engineering the vasculature with additive manufacturing. Curr. Opin. Biomed. Eng. 2017, 2, 1–13. [Google Scholar] [CrossRef]
- Chen, W.; Li, D.; Ei-Shanshory, A.; El-Newehy, M.; Ei-Hamshary, H.A.; Al-Deyab, S.S.; He, C.; Mo, X. Dexamethasone loaded core-shell SF/PEO nanofibers via green electrospinning reduced endothelial cells inflammatory damage. Colloids Surf. B Biointerfaces 2015, 126, 561–568. [Google Scholar] [CrossRef]
- Ehterami, A.; Salehi, M.; Farzamfar, S.; Vaez, A.; Samadian, H.; Sahrapeyma, H.; Mirzaii, M.; Ghorbani, S.; Goodarzi, A. In vitro and in vivo study of PCL/COLL wound dressing loaded with insulin-chitosan nanoparticles on cutaneous wound healing in rats model. Int. J. Biol. Macromol. 2018, 117, 601–609. [Google Scholar] [CrossRef]
- Najafiasl, M.; Osfouri, S.; Azin, R.; Zaeri, S. Alginate-based electrospun core/shell nanofibers containing dexpanthenol: A good candidate for wound dressing. J. Drug Deliv. Sci. Technol. 2020, 57, 101708. [Google Scholar] [CrossRef]
- Hu, M.; Li, C.; Li, X.; Zhou, M.; Sun, J.; Sheng, F.; Shi, S.; Lu, L. Zinc oxide/silver bimetallic nanoencapsulated in PVP/PCL nanofibres for improved antibacterial activity. Artif. Cells Nanomed. Biotechnol. 2018, 46, 1248–1257. [Google Scholar] [CrossRef] [Green Version]
- Miguel, S.P.; Ribeiro, M.P.; Coutinho, P.; Correia, I.J. Electrospun polycaprolactone/Aloe Vera_chitosan nanofibrous asymmetric membranes aimed for wound healing applications. Polymers 2017, 9, 183. [Google Scholar] [CrossRef]
- Münchow, E.A.; Albuquerque, M.T.P.; Zero, B.; Kamocki, K.; Piva, E.; Gregory, R.L.; Bottino, M.C. Development and characterization of novel ZnO-loaded electrospun membranes for periodontal regeneration. Dent. Mater. 2015, 31, 1038–1051. [Google Scholar] [CrossRef] [Green Version]
- Ramírez-Cedillo, E.; Ortega-Lara, W.; Rocha-Pizaña, M.R.; Gutierrez-Uribe, J.A.; Elías-Zúñiga, A.; Rodríguez, C.A. Electrospun polycaprolactone fibrous membranes containing Ag, TiO2 and Na2Ti6O13 particles for potential use in bone regeneration. Membranes 2019, 9, 12. [Google Scholar] [CrossRef] [Green Version]
- Tang, Y.; Lan, X.; Liang, C.; Zhong, Z.; Xie, R.; Zhou, Y.; Miao, X.; Wang, H.; Wang, W. Honey loaded alginate/PVA nanofibrous membrane as potential bioactive wound dressing. Carbohydr. Polym. 2019, 219, 113–120. [Google Scholar] [CrossRef]
- Yang, X.; Fan, L.; Ma, L.; Wang, Y.; Lin, S.; Yu, F.; Pan, X.; Luo, G.; Zhang, D.; Wang, H. Green electrospun Manuka honey/silk fibroin fibrous matrices as potential wound dressing. Mater. Des. 2017, 119, 76–84. [Google Scholar] [CrossRef]
- Minden-Birkenmaier, B.A.; Neuhalfen, R.M.; Janowiak, B.E.; Sell, S.A. Preliminary Investigation and Characterization of Electrospun Polycaprolactone and Manuka Honey Scaffolds for Dermal Repair. J. Eng. Fibers Fabr. 2015, 10, 155892501501000406. [Google Scholar] [CrossRef]
- Mouro, C.; Gomes, A.P.; Ahonen, M.; Fangueiro, R.; Gouveia, I.C. Chelidoniummajus L. Incorporated Emulsion Electrospun PCL/PVA_PEC Nanofibrous Meshes for Antibacterial Wound Dressing Applications. Nanomaterials 2021, 11, 1785. [Google Scholar] [CrossRef]
- Grant, J.J.; Pillai, S.C.; Perova, T.S.; Hehir, S.; Hinder, S.J.; McAfee, M.; Breen, A. Electrospun Fibres of Chitosan/PVP for the Effective Chemotherapeutic Drug Delivery of 5-Fluorouracil. Chemosensors 2021, 9, 70. [Google Scholar] [CrossRef]
- Musiał-Kulik, M.; Włodarczyk, J.; Stojko, M.; Karpeta-Jarząbek, P.; Pastusiak, M.; Janeczek, H.; Kasperczyk, J. Bioresorbable, electrospun nonwoven for delayed and prolonged release of temozolomide and nimorazole. Eur. J. Pharm. Biopharm. 2021, 161, 29–36. [Google Scholar] [CrossRef]
- Yan, E.; Jiang, J.; Yang, X.; Fan, L.; Wang, Y.; An, Q.; Zhang, Z.; Lu, B.; Wang, D.; Zhang, D. pH-sensitive core-shell electrospun nanofibers based on polyvinyl alcohol/polycaprolactone as a potential drug delivery system for the chemotherapy against cervical cancer. J. Drug Deliv. Sci. Technol. 2020, 55, 101455. [Google Scholar] [CrossRef]
- Figueira, D.R.; Miguel, S.P.; de Sá, K.D.; Correia, I.J. Production and characterization of polycaprolactone-hyaluronic acid/chitosan-zein electrospun bilayer nanofibrous membrane for tissue regeneration. Int. J. Biol. Macromol. 2016, 93, 1100–1110. [Google Scholar] [CrossRef]
- Hu, J.; Kai, D.; Ye, H.; Tian, L.; Ding, X.; Ramakrishna, S.; Loh, X.J. Electrospinning of poly(glycerol sebacate)-based nanofibers for nerve tissue engineering. Mater. Sci. Eng. C 2017, 70, 1089–1094. [Google Scholar] [CrossRef]
- Hu, J.; Song, Y.; Zhang, C.; Huang, W.; Chen, A.; He, H.; Zhang, S.; Chen, Y.; Tu, C.; Liu, J.; et al. Highly Aligned Electrospun Collagen/Polycaprolactone Surgical Sutures with Sustained Release of Growth Factors for Wound Regeneration. ACS Appl. Bio Mater. 2020, 3, 965–976. [Google Scholar] [CrossRef]
- Kong, X.; He, Y.; Zhou, H.; Gao, P.; Xu, L.; Han, Z.; Yang, L.; Wang, M. Chondroitin Sulfate/Polycaprolactone/Gelatin Electrospun Nanofibers with Antithrombogenicity and Enhanced Endothelial Cell Affinity as a Potential Scaffold for Blood Vessel Tissue Engineering. Nanoscale Res. Lett. 2021, 16, 62. [Google Scholar] [CrossRef]
- Movahedi, M.; Salehi, A.O.M.; Moezi, D.; Yarahmadian, R. In vitro and in vivo study of aspirin loaded, electrospun polycaprolactone–maltodextrin membrane for enhanced skin tissue regeneration. Int. J. Polym. Mater. Polym. Biomater. 2021, 1–11. [Google Scholar] [CrossRef]
- Adhikari, U.; An, X.; Rijal, N.; Hopkins, T.; Khanal, S.; Chavez, T.; Tatu, R.; Sankar, J.; Little, K.J.; Hom, D.B.; et al. Embedding magnesium metallic particles in polycaprolactone nanofiber mesh improves applicability for biomedical applications. Acta Biomater. 2019, 98, 215–234. [Google Scholar] [CrossRef]
- Luraghi, A.; Peri, F.; Moroni, L. Electrospinning for drug delivery applications: A review. J. Control. Release 2021, 334, 463–484. [Google Scholar] [CrossRef]
- Liao, C.; Li, Y.; Tjong, S.C. Bactericidal and Cytotoxic Properties of Silver Nanoparticles. Int. J. Mol. Sci. 2019, 20, 449. [Google Scholar] [CrossRef] [Green Version]
- Israili, Z.H. Antimicrobial properties of honey. Am. J. Ther. 2014, 21, 304–323. [Google Scholar] [CrossRef]
- Mandal, M.D.; Mandal, S. Honey: Its medicinal property and antibacterial activity. Asian Pac. J. Trop. Biomed. 2011, 1, 154–160. [Google Scholar] [CrossRef] [Green Version]
- Dryden, M.; Lockyer, G.; Saeed, K.; Cooke, J. Engineered honey: In vitro antimicrobial activity of a novel topical wound care treatment. J. Glob. Antimicrob. Resist. 2014, 2, 168–172. [Google Scholar] [CrossRef] [PubMed] [Green Version]
- Cooke, J.; Dryden, M.; Patton, T.; Brennan, J.; Barrett, J. The antimicrobial activity of prototype modified honeys that generate reactive oxygen species (ROS) hydrogen peroxide. BMC Res. Notes 2015, 8, 20. [Google Scholar] [CrossRef] [PubMed] [Green Version]
- Love, N.R.; Chen, Y.Y.; Ishibashi, S.; Kritsiligkou, P.; Lea, R.; Koh, Y.; Gallop, J.L.; Dorey, K.; Amaya, E. Amputation-induced reactive oxygen species are required for successful Xenopus tadpole tail regeneration. Nat. Cell Biol. 2013, 15, 222–228. [Google Scholar] [CrossRef] [PubMed] [Green Version]
- Dunnill, C.; Patton, T.; Brennan, J.; Barrett, J.; Dryden, M.; Cooke, J.; Leaper, D.; Georgopoulos, N.T. Reactive oxygen species (ROS) and wound healing: The functional role of ROS and emerging ROS-modulating technologies for augmentation of the healing process. Int. Wound J. 2017, 14, 89–96. [Google Scholar] [CrossRef]
- Hixon, K.R.; Klein, R.C.; Eberlin, C.T.; Linder, H.R.; Ona, W.J.; Gonzalez, H.; Sell, S.A. A Critical Review and Perspective of Honey in Tissue Engineering and Clinical Wound Healing. Adv. Wound Care 2019, 8, 403–415. [Google Scholar] [CrossRef]
- Rossi, M.; Marrazzo, P. The Potential of Honeybee Products for Biomaterial Applications. Biomimetics 2021, 6, 6. [Google Scholar] [CrossRef]
- Halstead, F.D.; Webber, M.A.; Oppenheim, B.A. Use of an engineered honey to eradicate preformed biofilms of important wound pathogens: An in vitro study. J. Wound Care 2017, 26, 442–450. [Google Scholar] [CrossRef] [Green Version]
- Dryden, M.; Dickinson, A.; Brooks, J.; Hudgell, L.; Saeed, K.; Cutting, K.F. A multi-centre clinical evaluation of reactive oxygen topical wound gel in 114 wounds. J. Wound Care 2016, 25, 140–146. [Google Scholar] [CrossRef] [Green Version]
- Aslan, E. Electrospun PCL-Surgihoney meshes for skin wound healing applications. In Proceedings of the 7th International Conference of Materials and Manufacturing Engineering, Thessaloniki, Greece, 2–3 July 2020; Volume 318. [Google Scholar]
- Hotaling, N.A.; Bharti, K.; Kriel, H.; Simon, C.G. DiameterJ: A validated open source nanofiber diameter measurement tool. Biomaterials 2015, 61, 327–338. [Google Scholar] [CrossRef] [Green Version]
- Philip, P.; Tomlal Jose, E.; Chacko, J.K.; Philip, K.C.; Thomas, P.C. Preparation and characterisation of surface roughened PMMA electrospun nanofibers from PEO—PMMA polymer blend nanofibers. Polym. Test. 2019, 74, 257–265. [Google Scholar] [CrossRef]
- Goikhman, A.S.; Irklei, V.M.; Vavrinyuk, O.S.; Pirogov, V.I. X-ray diffraction determination of the degree of crystallinity of cellulose using a computer. Fibre Chem. 1992, 24, 80–85. [Google Scholar] [CrossRef]
- Sami, A.; David, E.; Fréchette, M. Procedure for evaluating the crystallinity from X-ray diffraction scans of high and low density polyethylene/SiO2 composites. In In Proceedings of the 2010 Annual Report Conference on Electrical Insulation and Dielectic Phenomena, West Lafayette, IN, USA, 17–20 October 2010; pp. 2–5. [Google Scholar] [CrossRef]
- Kokubo, T.; Takadama, H. How useful is SBF in predicting in vivo bone bioactivity? Biomaterials 2006, 27, 2907–2915. [Google Scholar] [CrossRef]
- Bittiger, H.; Marchessault, R.H.; Niegisch, W.D. Crystal structure of poly-ε-caprolactone. Acta Crystallogr. Sect. B 1970, 26, 1923–1927. [Google Scholar] [CrossRef]
- Baji, A.; Wong, S.-C.; Liu, T.; Li, T.; Srivatsan, T.S. Morphological and X-ray diffraction studies of crystalline hydroxyapatite-reinforced polycaprolactone. J. Biomed. Mater. Res. Part B Appl. Biomater. 2007, 81B, 343–350. [Google Scholar] [CrossRef]
- Karimi, S.; Feizy, J.; Mehrjo, F.; Farrokhnia, M. Detection and quantification of food colorant adulteration in saffron sample using chemometric analysis of FT-IR spectra. RSC Adv. 2016, 6, 23085–23093. [Google Scholar] [CrossRef]
- Anubha, K.; Andrew, L.; Ahmad, A.-J. Mechanical Behaviour of Skin: A Review. J. Mater. Sci. Eng. 2016, 5, 1000254. [Google Scholar] [CrossRef] [Green Version]
- Sun, Y.; Tang, X.; Bao, H.; Yang, Z.; Ma, F. The effects of hydroxide and epoxide functional groups on the mechanical properties of graphene oxide and its failure mechanism by molecular dynamics simulations. RSC Adv. 2020, 10, 29610–29617. [Google Scholar] [CrossRef]
- Augustine, R.; Kalarikkal, N.; Thomas, S. In Vitro Degradation of Electrospun Polycaprolactone Membranes in Simulated Body Fluid. Int. J. Inst. Mater. Malays. 2014, 2, 211–220. [Google Scholar]
- Chouzouri, G.; Xanthos, M. In vitro bioactivity and degradation of polycaprolactone composites containing silicate fillers. Acta Biomater. 2007, 3, 745–756. [Google Scholar] [CrossRef]
- Janarthanan, G.; Kim, I.G.; Chung, E.-J.; Noh, I. Comparative studies on thin polycaprolactone-tricalcium phosphate composite scaffolds and its interaction with mesenchymal stem cells. Biomater. Res. 2019, 23, 1. [Google Scholar] [CrossRef] [Green Version]
- Buranasin, P.; Mizutani, K.; Iwasaki, K.; Pawaputanon Na Mahasarakham, C.; Kido, D.; Takeda, K.; Izumi, Y. High glucose-induced oxidative stress impairs proliferation and migration of human gingival fibroblasts. PLoS ONE 2018, 13, e0201855. [Google Scholar] [CrossRef]
- Zhang, X.; Stewart, J.A.; Kane, I.D.; Massey, E.P.; Cashatt, D.O.; Carver, W.E. Effects of elevated glucose levels on interactions of cardiac fibroblasts with the extracellular matrix. Vitr. Cell. Dev. Biol. Anim. 2007, 43, 297–305. [Google Scholar] [CrossRef]
- Chambers, A.C.; Leaper, D.J. Role of oxygen in wound healing: A review of evidence. J. Wound Care 2011, 20, 160–164. [Google Scholar] [CrossRef]

Publisher’s Note: MDPI stays neutral with regard to jurisdictional claims in published maps and institutional affiliations. |
© 2021 by the authors. Licensee MDPI, Basel, Switzerland. This article is an open access article distributed under the terms and conditions of the Creative Commons Attribution (CC BY) license (https://creativecommons.org/licenses/by/4.0/).
Share and Cite
Aslan, E.; Vyas, C.; Yupanqui Mieles, J.; Humphreys, G.; Diver, C.; Bartolo, P. Preliminary Characterization of a Polycaprolactone-SurgihoneyRO Electrospun Mesh for Skin Tissue Engineering. Materials 2022, 15, 89. https://doi.org/10.3390/ma15010089
Aslan E, Vyas C, Yupanqui Mieles J, Humphreys G, Diver C, Bartolo P. Preliminary Characterization of a Polycaprolactone-SurgihoneyRO Electrospun Mesh for Skin Tissue Engineering. Materials. 2022; 15(1):89. https://doi.org/10.3390/ma15010089
Chicago/Turabian StyleAslan, Enes, Cian Vyas, Joel Yupanqui Mieles, Gavin Humphreys, Carl Diver, and Paulo Bartolo. 2022. "Preliminary Characterization of a Polycaprolactone-SurgihoneyRO Electrospun Mesh for Skin Tissue Engineering" Materials 15, no. 1: 89. https://doi.org/10.3390/ma15010089
APA StyleAslan, E., Vyas, C., Yupanqui Mieles, J., Humphreys, G., Diver, C., & Bartolo, P. (2022). Preliminary Characterization of a Polycaprolactone-SurgihoneyRO Electrospun Mesh for Skin Tissue Engineering. Materials, 15(1), 89. https://doi.org/10.3390/ma15010089

